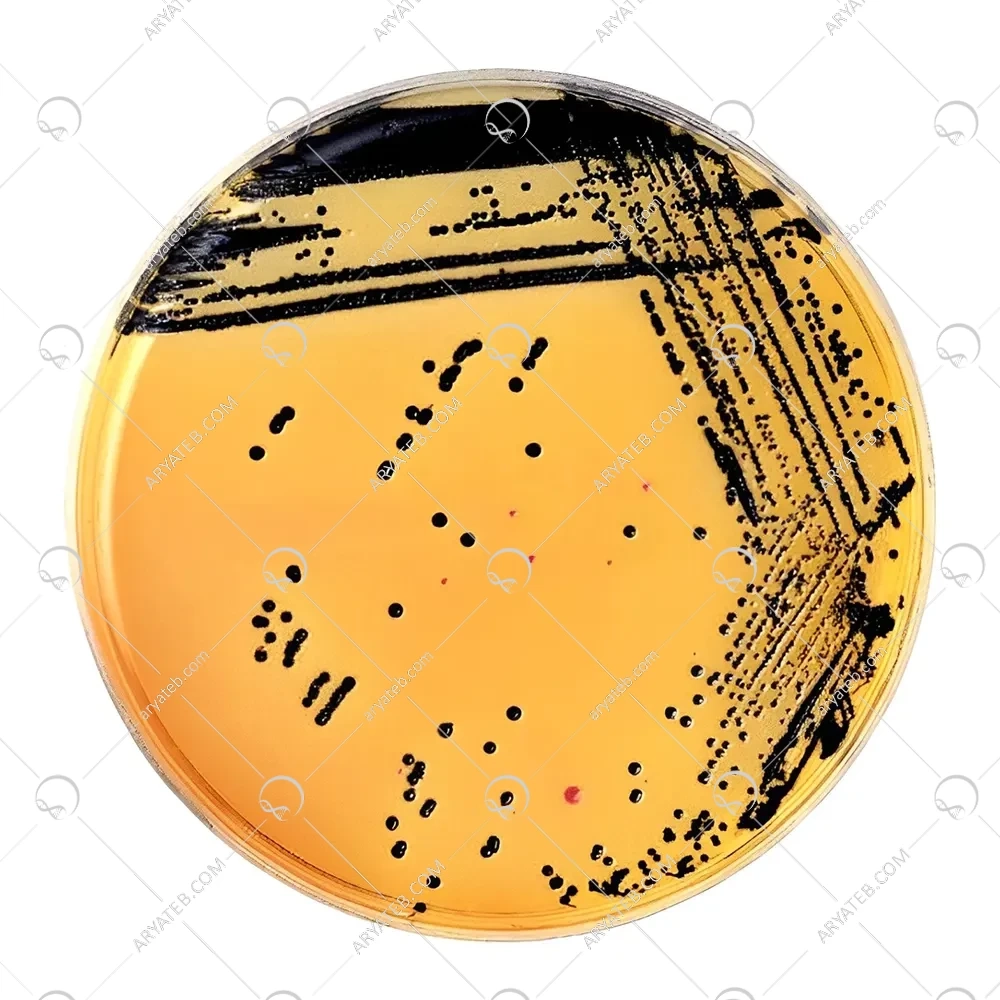

محیط کشت وی جی آگار VJ agar
- Vogel Johnson Agar Tellurite
محیط کشت وی جی آگار
محیط کشت شامل محل رشد انواع باکتری و میکروب ها با گونه های مختلف می باشد که حالت های مختلفی دارند که به صورت ژله ای و جامد یا آبگوشتی بوده است که با توجه به نوع باکتری ترکیبات مغذی چون کربن یا آب استفاده می شود که هدف اصلی جرگه گیری باکتری ها بوده است تا از ترکیبات ساخته شده مواد کمی را استفاده کنند که عناصر حیاتی فاقد هر نوع اسید و آمینو اسیدی بوده است که این محیط فقط محل رشد میکروب ها بوده و محل انتخابی رشد جانداران نمی باشد دو نوع می باشد که اصول هر یک با نام خرد زیستی و یاخته ای آشنا است .
نوع محیط کشت وی جی آگار انتخابی بوده است که واکنش شمارش را در پی دارد آگار موجود در محیط کشت وی جی پودری بوده که بر حسب گرم در نحوه ی آماده سازی محیط استفاده می شود که اثر قوی دارد این اثرگذاری به اصطلاح قوی در محیط به راحتی هرنوع بیماری که آسیب می رساند به استافیلوکوک را به راحتی شناسایی می کند و به راحتی ارگانیسم های تولید شده را مهار می کند زیرا دارنده ی یک تخمیر مانیتولی ثابتی می باشند که عمل ثابت را به همراه دارد.
برای انتخاب نوع انتخابی و اثرگذاری محیط باید فرایند پیشرفت جلوگیری ۲۴ ساعت را در نظر داشته باشید تا تلقیح سنگین را مجاز نماید تا باکتری های کوچک مانیتول تخمیری را فرا سازند که شناسایی جداگانه ای دارند و جداسازی به صورت غذایی یا بالینی انجام می گردد که نوع مثبت دارد از این رو در جهت تشخیص مخمر مانیتول مثبت سرعت عمل بالایی دارد که تبدیل به محیط آبکاری با سرعت کمی شده است.
محیط کشت VJ agar
اصول رویه کشی محیط آبکاری همراه با ویتامین ها و عصاره های مخمری بوده است که در صورتی که اورگانیسم تولید شده رعایت حائز برای تولید استافیلوکوکی نداشته باشد حاصل به پتاشیم می شود که هر دو لازم به مهارسازی بوده اند و یک محلول قرمز رقیق شده در ۶ دهم درصد آب بوده کمی دارنده ی رسوب سفید متمایل به قرمز را دارد نوع بسته بندی محیط کشت وجی آگار به دلیل پودری در بطری بوده است طوری که فرمت تولید به صورت کم اب بوده تا به محلول رقیق دست یابد دارنده ی فرمول های پارامتر شده در حد استاندارد می باشد کل محصول ۱۰۰ گرم بوده است که ازمایش حد میکروبی را به درستی ایفا می کند که این میکروب مشترکی بین پوست و مخاط انسانی است و هیچ اورگانیسم آلوده به رنگ زرد ندارد.
آدرس ایمیل شما منتشر نخواهد شد. فیلدهای الزامی علامت گذاری شده اند *